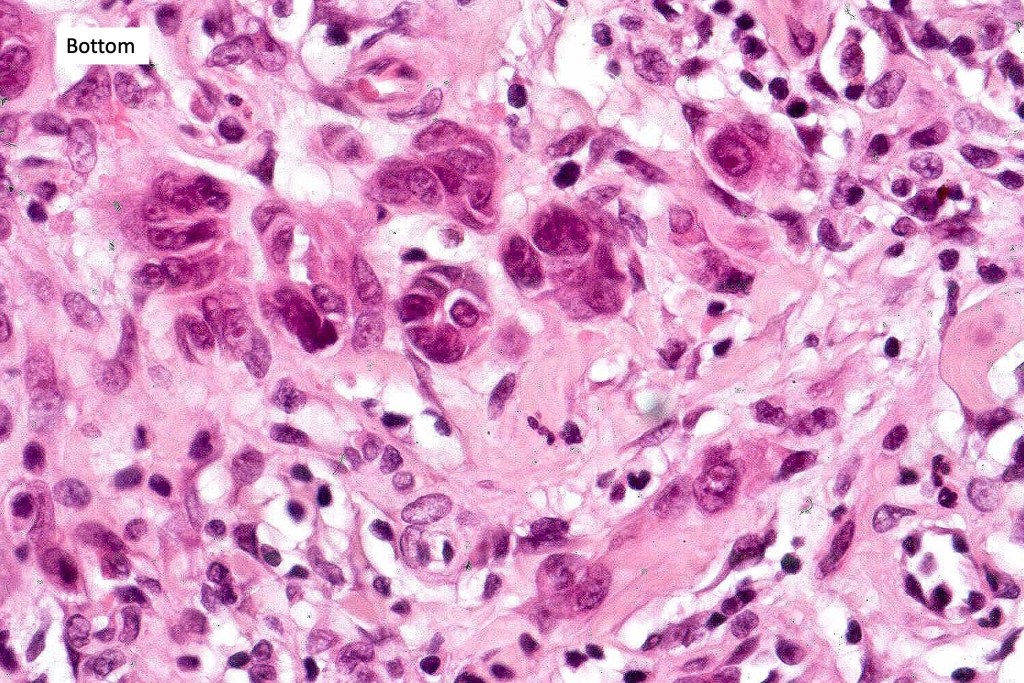
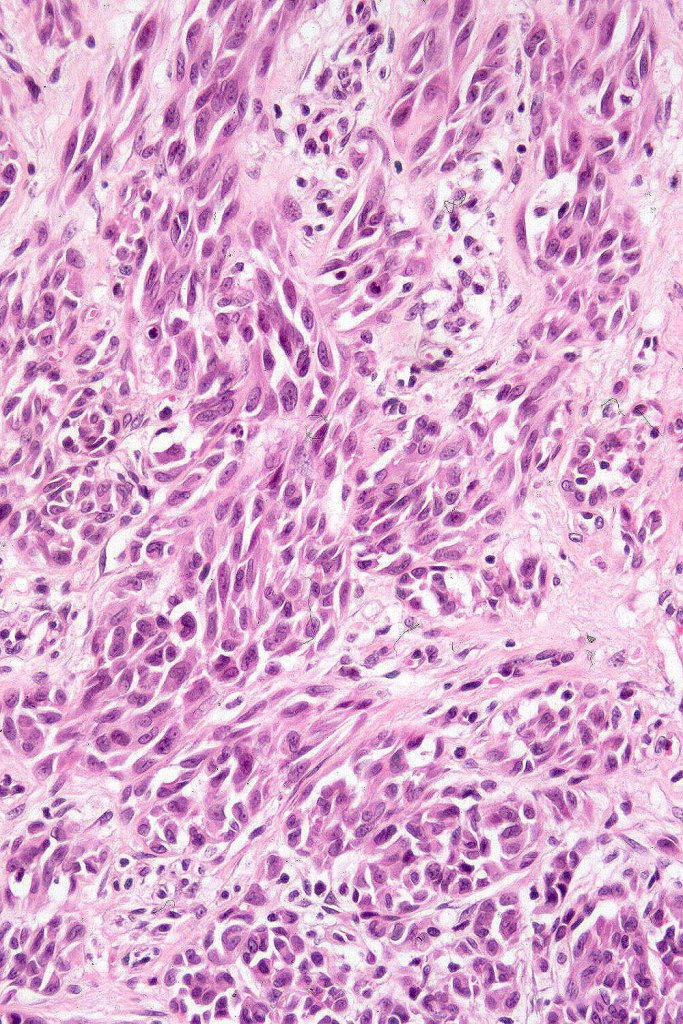
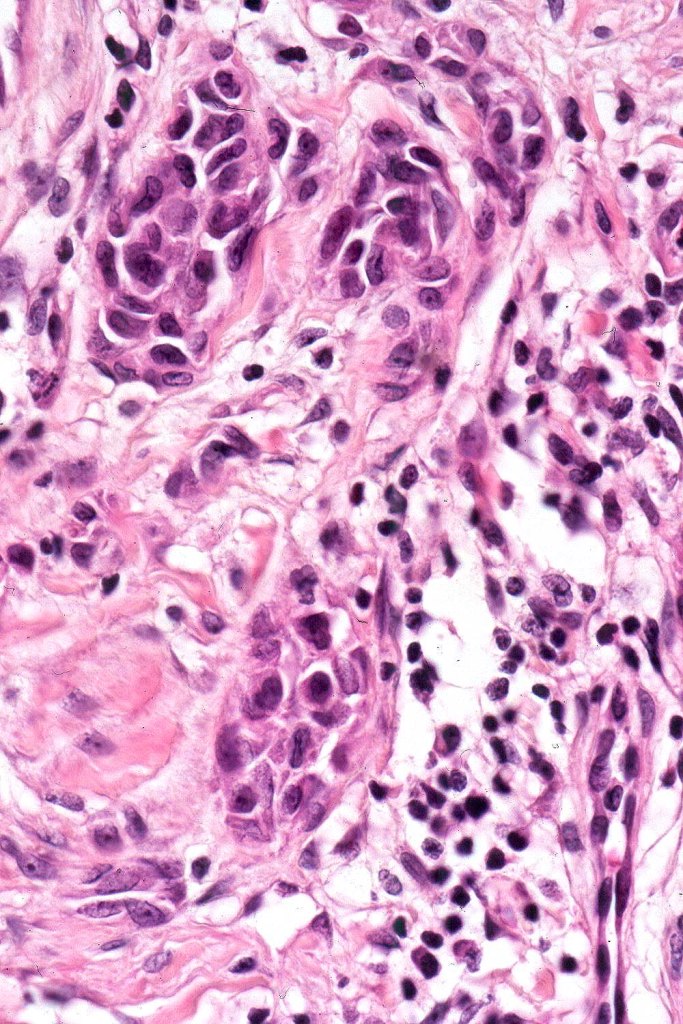
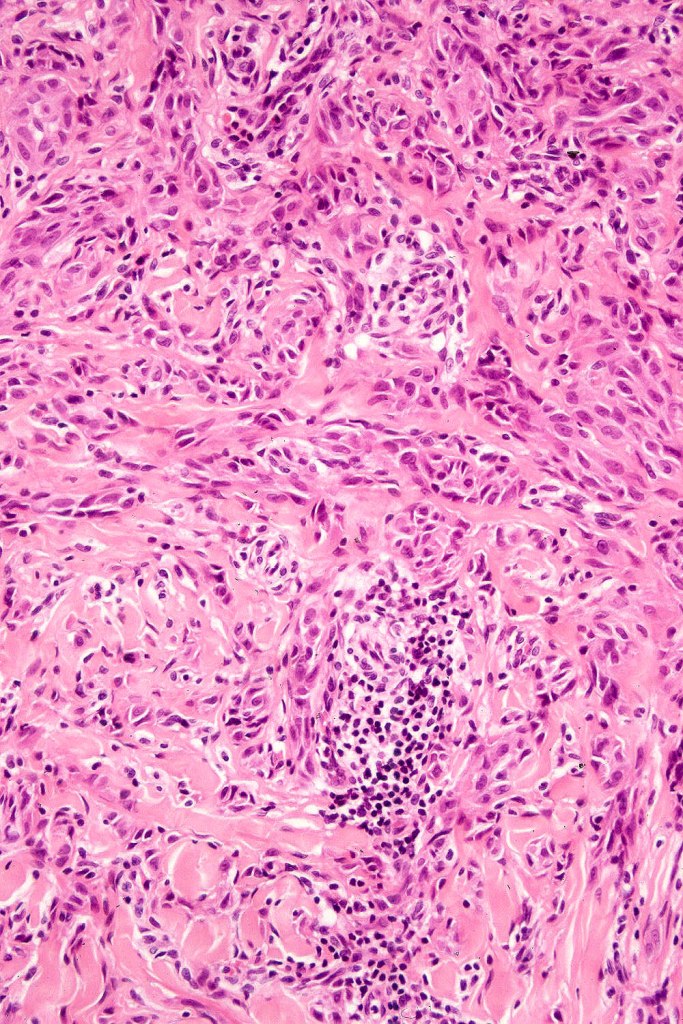
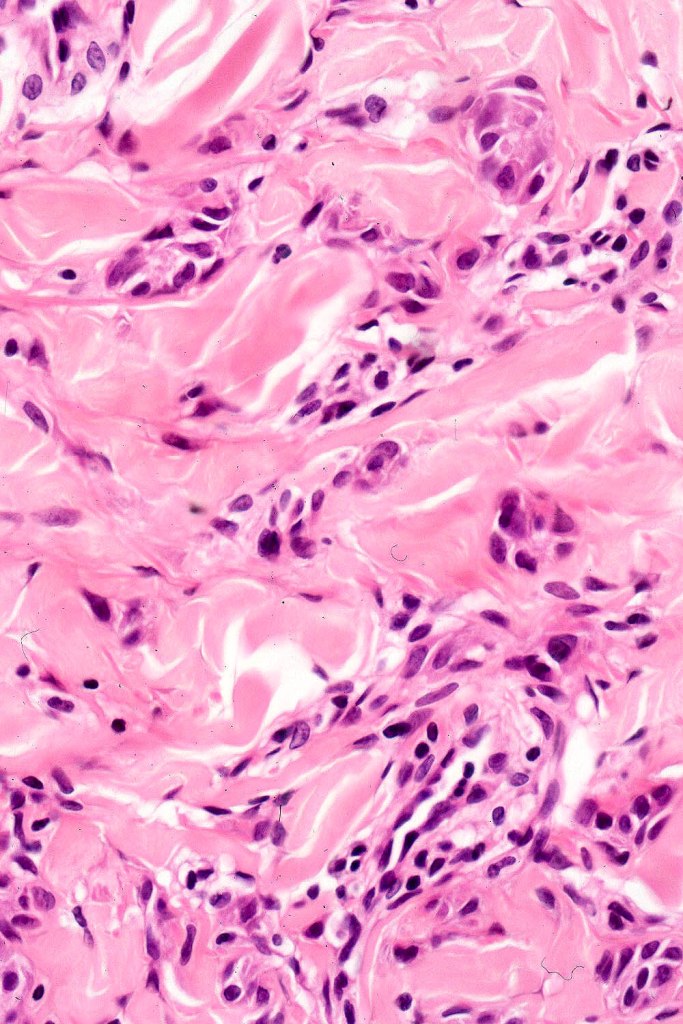
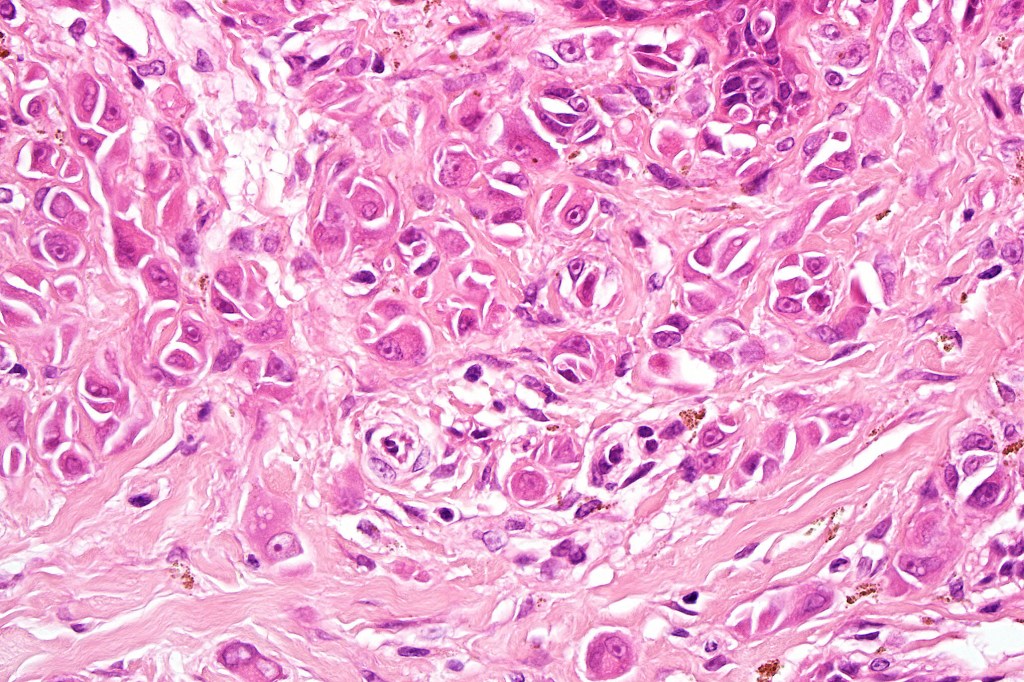
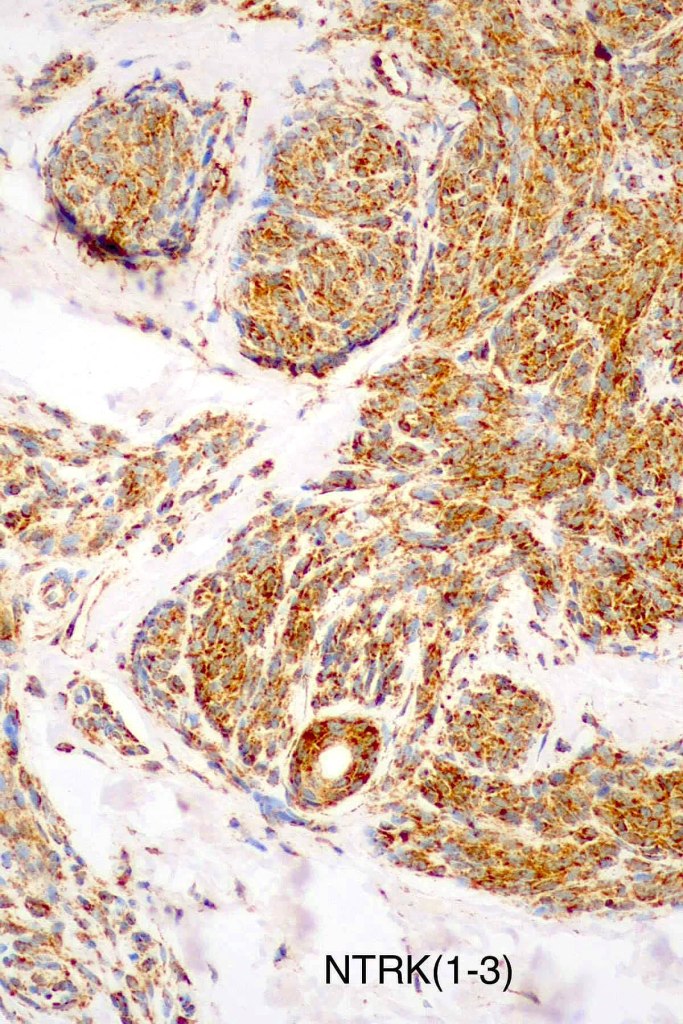
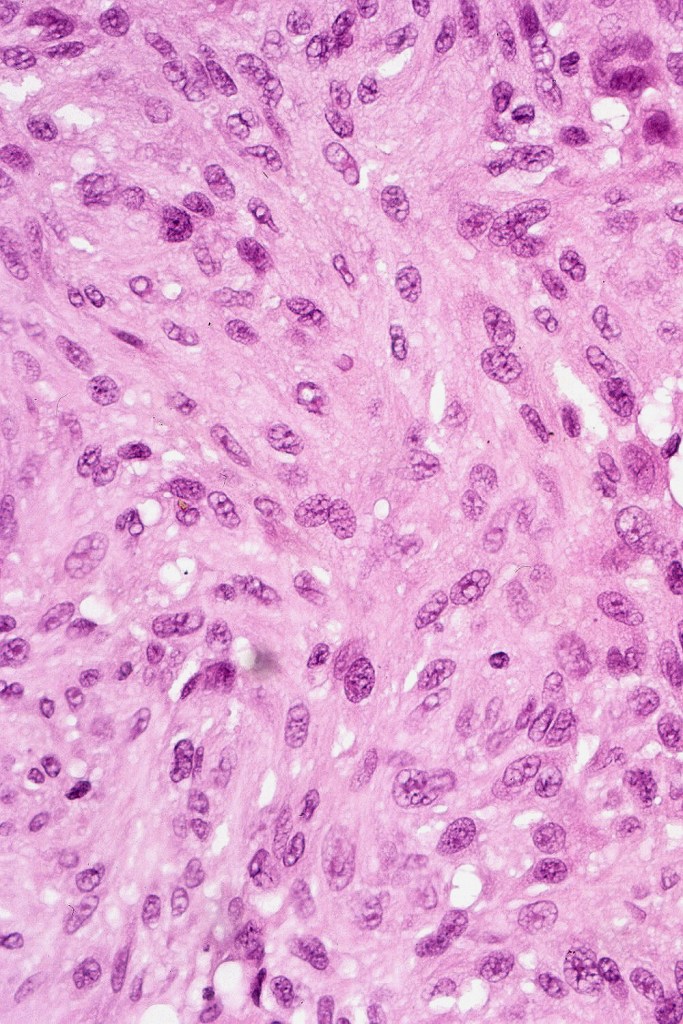
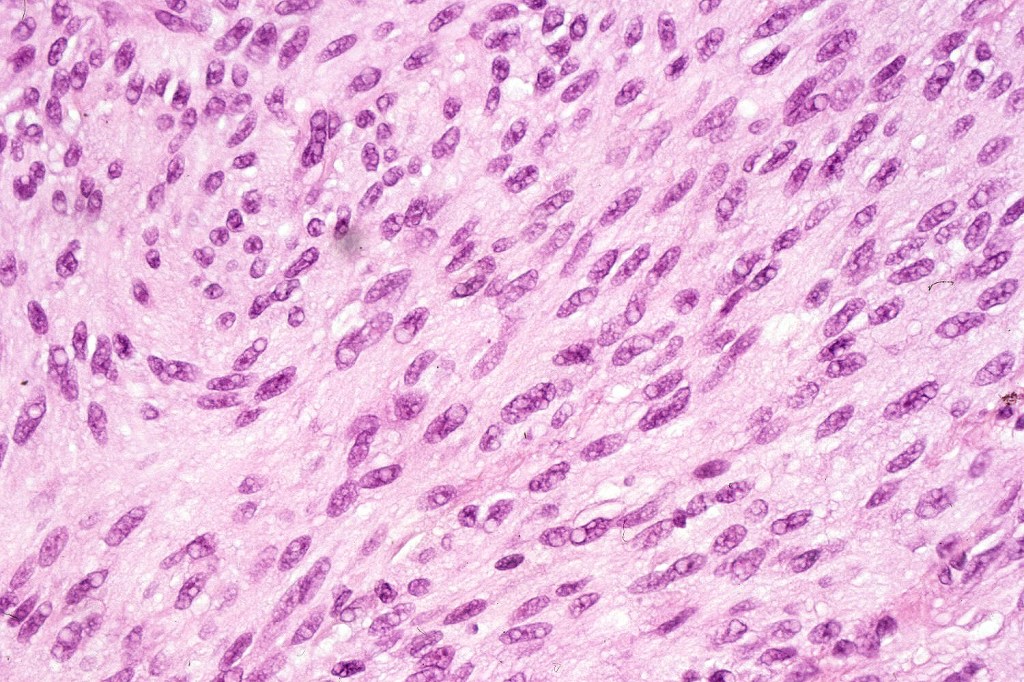
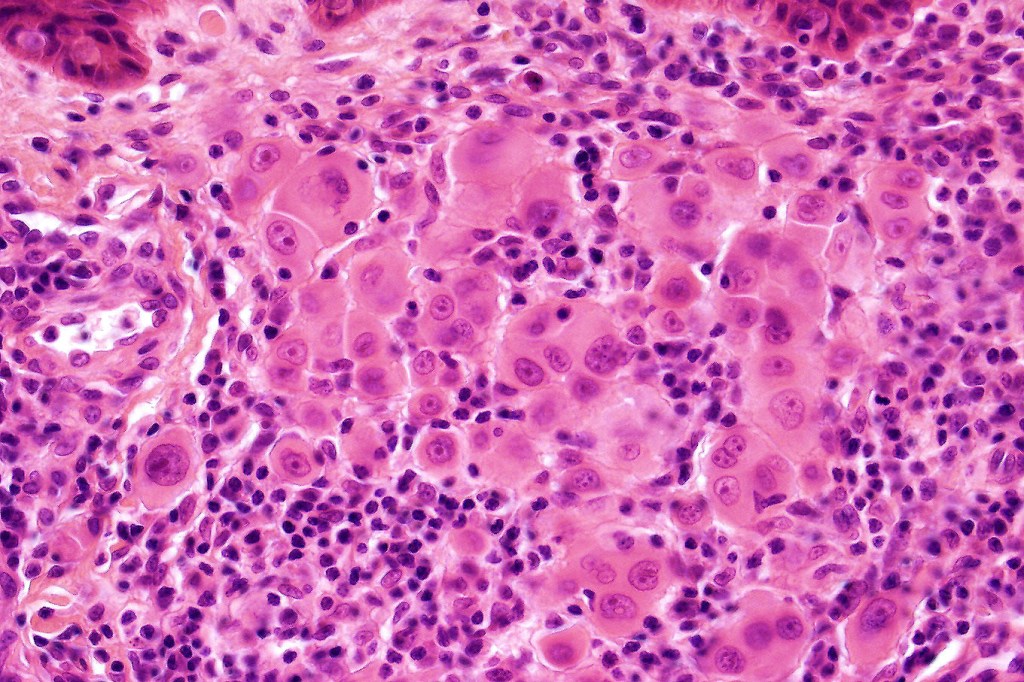
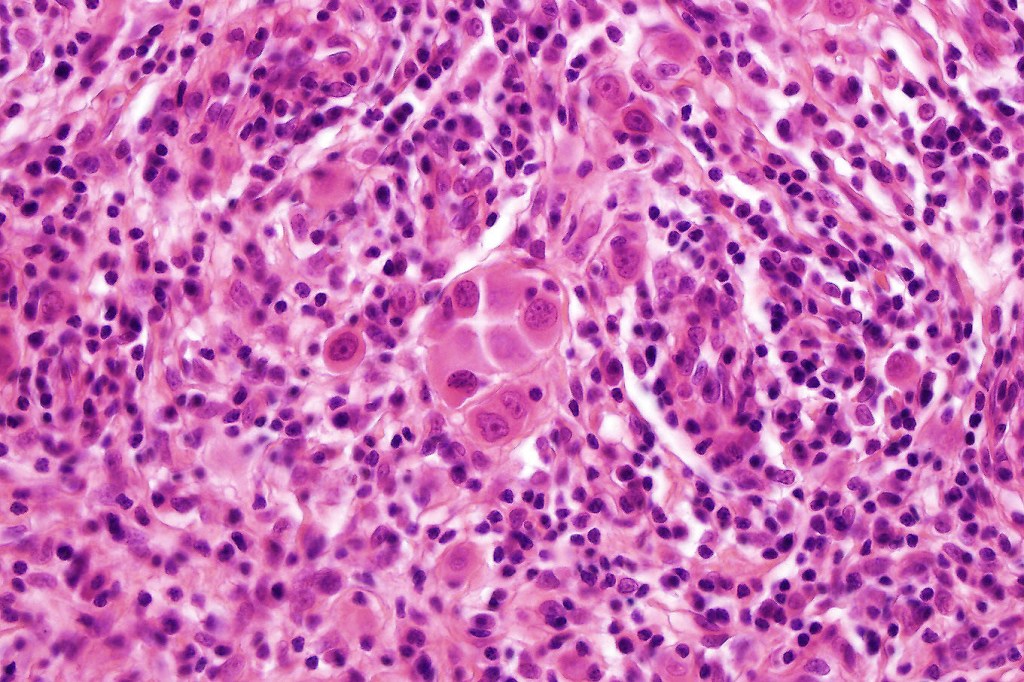
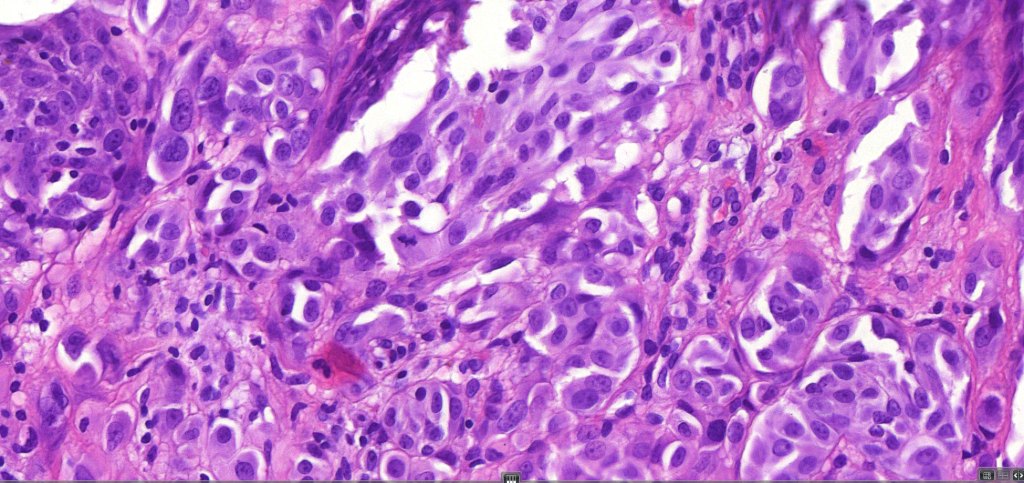
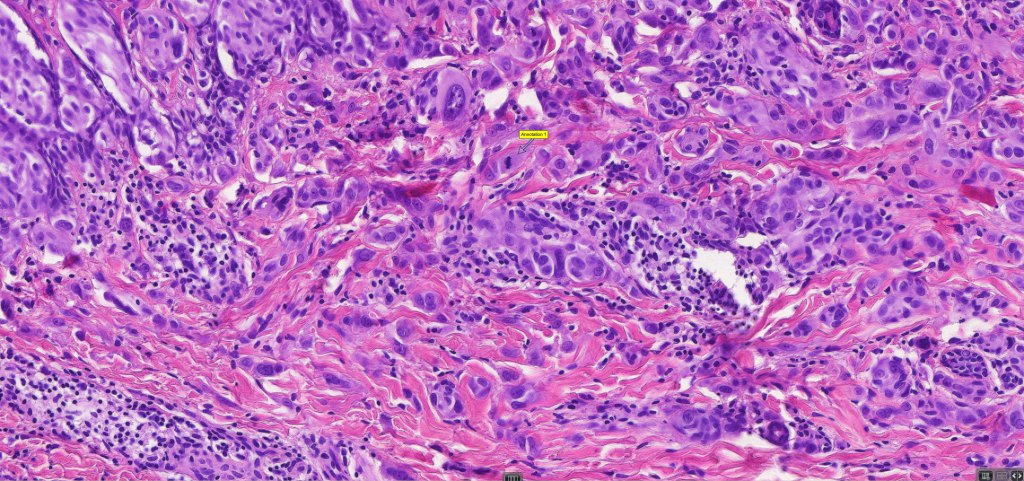

Clinical features
•In the older literature also known as juvenile melanoma, spindle & epithelioid cell nevus
•First described by Sophie Spitz in 1948
•Approximately 1% of nevi in children
•Most often presents in children & adolescents but may be seen the middle aged
•Although cases have been documented in the elderly, I would advise extreme caution in making such a diagnosis, the lesion is considerably more likely to represent a melanoma.
•Pink/erythematous/red-brown rapidly growing papule or nodule generally measuring 1.0 cm in diameter or less
.Incomplely excised lesions often tend towards spontaneous regression
•Macular (intra-epidermal/junctional Spitz nevus), polypoid & verrucous variants
•Multiple grouped lesions (agminate Spitz nevus)
•Zosteriform agminate Spitz nevus
•Eruptive Spitz nevus (widespread distribution)
•Halo Spitz nevus
•Lesions are most commonly encountered on the face (especially the cheek) trunk and extremities but can present just about anywhere
. Sometimes clinically mistaken for a pyogenic granuloma
. The classical dermatoscopic appearance is that of a vascular pattern presenting as dotted vessels or red globules



Histological features, immunohistochemistry & molecular data
•Sharply circumscribed (begins and ends with a nest), symmetrical dome-shaped lesion. Symmetry is both horizontal and vertical (see image below)
•Wedge-shaped with the base uppermost or sometimes plaque-shaped silhouette
•Matures with depth-often best recognized at scanning/low power magnification & readily confirmed with S100 or MART1
•Maturation implies nest size and cell size diminishing with depth, at the base, the infiltrate may have a single cell infiltrating pattern
•Hyperkeratosis & acanthosis, sometimes very marked
•Pseudoepitheliomatous hyperplasia
. Pigmentation variable ranging for amelanotic to heavily pigmented
•Superficial vascular ectasia very frequently present
•Spindle, epithelioid and mixed cell variants
•Junctional nests often vertically orientated, dyscohesive with a surrounding retraction artifact
•Pleomorphism is almost invariable but affects all of the population to the same extent i.e., the cells & nuclei all look very much the same
•Spindle cell nests often display a “raining down” growth pattern
•Spindle cells have abundant cytoplasm and vesicular nuclei with small nucleoli
•Epithelioid cell variants often show greater pleomorphism and cells can frequently appear bizarre with abundant, sometimes ground glass cytoplasm and large vesicular nuclei with prominent eosinophilic nucleoli, multinucleate cells are often seen
•Intracytoplasmic pseudoinclusions commonly present in epithelioid cells
•Mitoses can brisk in younger patients and should not be taken as indicating melanoma
•Mitoses are restricted to the superficial aspect on the nevus and are never atypical
•Single cell Pgetoid spread may be seen in the center of the nevus or transpeidermal elimination of nests
•Kamino bodies (often multiple) are a characteristic feature
•Lymphocytic infiltration at the base of the lesion
•Combined variants
•BAP1-inactivated melanocytoma may have a Spitzoid morphology
•Spitz nevus has been shown to be associated with receptor tyrosine kinase mutations including ALK, ROS, RET, & NTRK1-3, MET, mutations in HRAS or MAP2Ki, copy number gains of 11p
•S100, MART1 & SOX10 +ve, HMB45 +ve (superficially & lost progressively with depth), p16 +ve, p21 +ve
. Ki67 +ve in a small minority of cells
. BRAF -ve

Histological variants of Spitz nevus
•Pagetoid (see separate blog)
•Desmoplastic (see separate blog)
•Spindle cell nevus of Reed (see separate blog)
•Hyalinized
•Plexiform
•Angiomatoid
•Rosette-like
•Tubular
•Signet-ring cell
•Verrucous
.Polypoid
Plexiform Spiz nevus

Atypical Spitz nevus/tumor
The term atypical Spitz nevus/tumor was introduced as a means of separating out those lesions which show features of a Spitz nevus with some but not all of those seen in melanoma. It implies diagnostic uncertainty. While the reason for its introduction is laudable, the term has been inappropriately abused by some for any Spitz nevus showing the slightest deviation from the classical features. The term has turned into a dumping ground particularly for the inexperienced. Although not completely true, the statement by the late Bernie Ackerman that “atypical Spitz nevus comprises an admixture of Spitz nevi and melanoma” with nothing else has merit. The term should not be applied lightly as it is certainly associated with risk of sentinel node spread & sometimes beyond. I have never been keen on the entity. While I agree that not all cases are readily characterized as benign or malignant, I do believe that the over whelming majority of cases can and should be. I used to tell the residents and fellows the following potted history. A patient was noticed by his/her partner to have an odd pigmented lesion on the back. The patient went to the general practitioner who agree that it was odd and arranged for a dermatology referral. The dermatologist also thought that it was odd and excised it. The pathologist agreed that it was odd but didn’t know if it was benign or malignant. The patient and his/her partner wondered why they has bothered worring about it in the first place!
The advent of the molecular era has resulted in the re-classification of many of these lesions. Features which are often used in the diagnose of atypical Spitz nevus include:
Large size
Impaired circumscription and asymmetry
Ulceration
Excessive Pagetoid spread
Absence of Kamino bodies
Expansile dermal nests (these are particularly worrysome as they are common and important feature of melanoma)
Imapired maturation
Pushing deep border (in Spitz nevus, the lower border typically infiltrates the adjacent dermis)
Excessive mitotic activity,
Deep mitoses,
Atypical mitoses (although these are seen much more often in Spitz/Spitzoid melanoma)
It is stressed that the presence of only some of these features are consistent with the diagnosis of atypical Spitz nevus. If many are present, it is much more lkely that the lesion is a melanoma.

Leave a comment